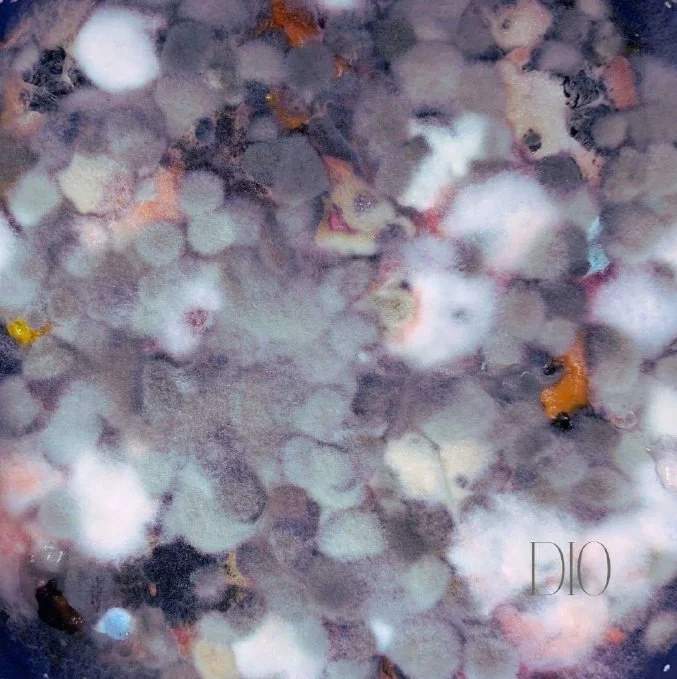

Golden Caps
Género(s) musical(es) del proyecto:
Rock, Pop, Psicodélico.
Descripción del proyecto:
Golden Caps es la exploración de la melodía clásica y pop sobre una serie de acidas tensiones armónicas que llevan el sonido por ambientes que naturalmente no se identifican estrictamente con un género musical y por ello se mueve libremente en todo tipo de vanguardia y escena artística. La banda ha llegado a establecer un sonido propio, no encasillado, y en continua evolución.
Integrantes:
Majo Santana (cantante, diseñadora gráfica), Manuel Cadena (guitarrista), Beto Almendarez (bajista, productor musical),
Ismael Graciano (guitarra) y Alan Vera (baterista).
Año de comienzo:
2018